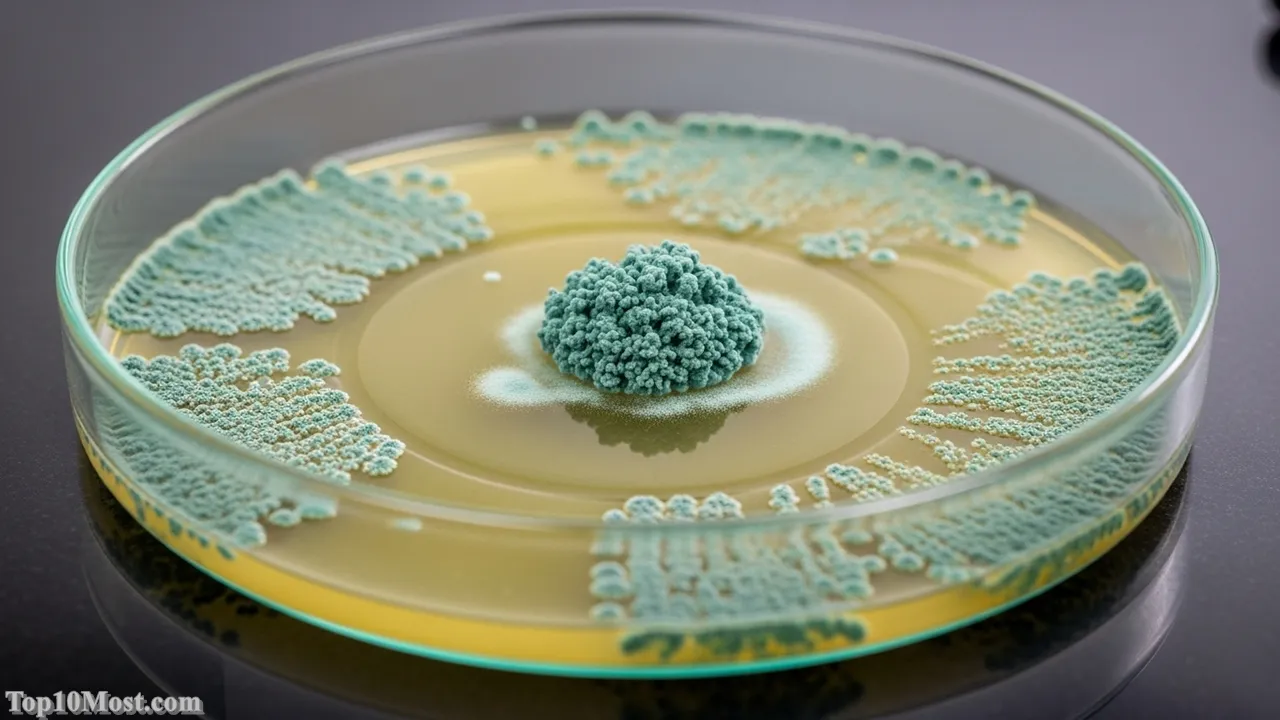
Top 10 Most Important Medical Discoveries

The history of medicine is a testament to human curiosity and resilience, a relentless campaign against disease and early mortality. At Top 10 Most, we explore, compare, and explain what truly stands above the rest. Every ranking represents our reasoned analytical perspective—the sheer number of lives saved, the diseases eradicated, and the foundational knowledge they provided for all subsequent science. As of late 2025, the global health landscape is defined by the promise of molecular biology and gene therapy, yet the greatest milestones remain the century-old advances that fundamentally altered the human lifespan.
This list reflects our reasoned analytical perspective on the most impactful medical breakthroughs, ranging from the earliest understanding of disease transmission to the modern marvels of genetic engineering. Every entry is selected for its profound, verifiable, and enduring contribution to global public health and the quality of human life.
We don’t just rank these life-changing advances; we explain the MEANING behind their greatness, ensuring that our readers grasp the full weight of their contribution to a healthier, longer future, all supported by credible data current through November 2025.
Table of the Top 10 Most Important Medical Discoveries
| Rank | Discovery | Pioneers (Key Figures) | Year of Discovery | Primary Impact/Significance |
|---|---|---|---|---|
| 1 | Germ Theory | Louis Pasteur, Robert Koch, Joseph Lister | 1861-1890s | Established that microbes cause disease, leading to sanitation and sterilization. |
| 2 | Vaccination (Smallpox) | Edward Jenner | 1796 | First successful immunization; led to the global eradication of a major disease. |
| 3 | Antibiotics (Penicillin) | Alexander Fleming, Howard Florey, Ernst Chain | 1928 | The first effective treatment for bacterial infections; saved hundreds of millions of lives. |
| 4 | Surgical Anesthesia | William Morton, John Collins Warren, James Simpson | 1846 (Public Demo) | Made complex, painless surgery possible, transforming an execution into a treatment. |
| 5 | Insulin Therapy | Frederick Banting, Charles Best, John Macleod, James Collip | 1921 | Turned Type 1 Diabetes from a death sentence into a manageable chronic condition. |
| 6 | DNA Structure & Genetics | James Watson, Francis Crick, Rosalind Franklin, Maurice Wilkins | 1953 | Unveiled the blueprint of life, foundational to modern molecular medicine and genetics. |
| 7 | Medical Imaging (X-Ray, MRI) | Wilhelm Röntgen, Paul Lauterbur, Peter Mansfield | 1895 (X-Ray) | Enabled non-invasive internal diagnosis, revolutionizing detection of injury and disease. |
| 8 | Public Sanitation/Water Chlorination | John Snow, Numerous Public Health Officials | 1854 (Cholera) | The most effective public health measure against waterborne diseases; extended life expectancy. |
| 9 | Organ Transplantation & Immunosuppression | Joseph Murray, Christiaan Barnard, Thomas Starzl | 1954 (Kidney) | Allowed replacement of failing organs, creating a new field of curative surgery. |
| 10 | mRNA Technology | Katalin Karikó, Drew Weissman | 2005 onwards | A platform for rapid vaccine development (COVID-19) and future personalized therapies. |
Top 10. mRNA Technology
The discovery and eventual mass application of messenger RNA (mRNA) technology represent one of the most exciting and rapidly deployed breakthroughs of the 21st century. While the foundational research has been ongoing for decades, the technology’s moment of definitive importance arrived with the unprecedented speed of the COVID-19 vaccine development in the early 2020s. This platform, pioneered by figures like Katalin Karikó and Drew Weissman, essentially teaches the body’s own cells to produce a protein fragment that triggers an immune response, providing a new, versatile tool in the fight against pathogens.

Its high ranking, despite its relative youth, is justified by its potential as a platform technology. Unlike traditional vaccines that require growing weakened viruses or protein segments, mRNA vaccines are designed and manufactured chemically, allowing for rapid adaptation to new viral variants and the pursuit of complex targets. As of November 2025, the focus is expanding beyond infectious diseases to potential personalized cancer treatments, using the patient’s own tumor profile to create a custom, targeted immune booster, marking a new era of ultra-personalized medicine.
The sheer speed and efficacy with which it addressed a global pandemic cemented its legacy, and the ongoing trials into new applications—from flu to HIV—confirm its status as a paradigm shift. This technology signifies a move toward information-based biology, where genetic code itself becomes the therapeutic agent, heralding a future where the molecular instructions for cure are written and delivered directly to the cellular machinery.
Key Highlights:
- Platform Versatility: Can be quickly adapted for new pathogens (demonstrated during the COVID-19 pandemic).
- Mechanism: Utilizes the body’s cells to produce the necessary antigens, leading to a strong immune response.
- Future Applications: Currently being trialed for cancer immunotherapy, flu, and other complex viral infections.
- Nobel Recognition: Katalin Karikó and Drew Weissman were awarded the 2023 Nobel Prize for this work.
Top 9. Organ Transplantation & Immunosuppression
The successful transplantation of whole, functional organs fundamentally redefined the concept of medical intervention, turning certain death from organ failure into a potentially curative state. This journey began in earnest with Dr. Joseph Murray’s first successful kidney transplant between identical twins in 1954, but it was the subsequent understanding and chemical control of the immune system that truly transformed the field. Discoveries in immunosuppressive drugs, such as cyclosporine, were as important as the surgical techniques themselves, allowing the recipient’s body to accept a foreign organ.

The reason this breakthrough is ranked here is because it established the viability of replacement biology. Before this, a failing heart or liver was an absolute limit; afterward, it became a surgical challenge. The development of anti-rejection protocols by pioneers like Thomas Starzl made complex procedures like liver transplants routine, saving tens of thousands of lives globally each year and paving the way for advanced regenerative medicine and the development of artificial organs still in progress in 2025.
This discovery is a powerful, reflective moment in medical history, forcing us to grapple with profound ethical and biological questions about identity, life support, and the definition of death. The image of a transplanted heart beating in a new chest remains one of the most compelling and dramatic symbols of modern medical triumph, proving that the human body could be rebuilt piece by piece.
Key Highlights:
- First Success: 1954 successful human kidney transplant by Joseph Murray.
- Game Changer: The development of effective immunosuppressant drugs, preventing organ rejection.
- Impact: Treatment for end-stage heart, lung, liver, and kidney failure.
- Ethical Foundation: Established the complex medical and legal framework for organ donation.
Top 8. Public Sanitation & Water Chlorination
While less glamorous than a new vaccine or a complex surgery, the implementation of Public Sanitation and Water Chlorination arguably represents the single most important and cost-effective public health measure in history. The crucial insight came from London physician John Snow in 1854, who famously linked a cholera outbreak to a contaminated public water pump by mapping the cases, proving that disease could be prevented not just cured. This epidemiological milestone led directly to the construction of modern sewage systems and the widespread practice of chemically treating public drinking water.

This discovery ranks highly because its impact is measured not in saved individual lives, but in the radical increase of global life expectancy—the baseline of modern civilization. The removal of human waste from drinking supplies virtually eliminated waterborne scourges like cholera, typhoid, and dysentery in developed nations. This preventative infrastructure, established over a century ago, continues to protect billions of people from deadly, easily transmissible bacterial diseases every single day, making it a foundation of modern health.
The simple clarity of John Snow’s work—a single, contaminated pump was the source—serves as a timeless reminder that health is often a product of effective engineering and public policy, not just medical treatment. Without the clean water that Top 10 Most readers take for granted in November 2025, most other medical advancements would have struggled to make a widespread impact against rampant infection.
Key Highlights:
- Foundational Insight: John Snow’s 1854 map-based tracing of the London cholera outbreak.
- Global Impact: Virtually eliminated major waterborne diseases (cholera, typhoid) in developed nations.
- Life Expectancy: Accounted for a major portion of the 20th-century increase in human lifespan.
- Method: Simple, large-scale intervention (sewer systems, water treatment) with massive effect.
Top 7. Medical Imaging (X-Ray, MRI, CT)
The ability to see inside the living human body without resorting to invasive surgery revolutionized both diagnosis and treatment planning. This era began with German physicist Wilhelm Röntgen’s accidental discovery of the X-ray in 1895, where he observed that these invisible rays could pass through flesh to cast shadows of dense bone structures. This was followed by the later development of sophisticated technologies like the Computed Tomography (CT) scan and Magnetic Resonance Imaging (MRI) in the mid-to-late 20th century, which provide unparalleled soft-tissue detail.

Medical imaging earns its place because it transformed medicine from a purely reactive, symptomatic practice into a visual, diagnostic science. From quickly identifying a broken bone in an emergency room to detecting a deep, nascent tumor that would be impossible to feel, these technologies are the silent, constant partners of virtually every specialist today. They allow for the early, precise detection necessary for successful treatment pathways, significantly improving prognosis across oncology, cardiology, and traumatology.
The X-ray’s almost immediate adoption globally speaks to the profound power of this visualization. It was the first tool that allowed physicians to peer past the surface, lending tangible proof to internal ailments and setting the stage for the highly detailed, molecular-level imaging techniques that continue to evolve rapidly as of November 2025.
Key Highlights:
- Initial Discovery: X-ray by Wilhelm Röntgen in 1895 (first non-invasive imaging).
- Diagnostic Cornerstone: Essential for emergency medicine, oncology, and cardiology.
- Advanced Tools: MRI and CT scans provide high-resolution soft-tissue and cross-sectional detail.
- Impact: Enables early and precise diagnosis, significantly improving treatment outcomes.
Top 6. DNA Structure & Genetics
The 1953 revelation of the double helix structure of DNA by James Watson and Francis Crick, building on the critical work of Rosalind Franklin and Maurice Wilkins, unlocked the fundamental blueprint of life itself. This discovery provided a physical, chemical model for how genetic information is stored, copied, and transmitted across generations. Before this, heredity was a mystery; afterward, it became a code waiting to be read, edited, and understood.

This breakthrough is ranked as a cornerstone because it is the foundation of all modern molecular medicine. While it didn’t immediately save lives like an antibiotic, it made all subsequent genetic and molecular research possible, including the Human Genome Project, gene therapy, personalized medicine, and the CRISPR/Cas9 gene-editing technology being developed in 2025. It transformed biology from a descriptive science into an informational one, allowing researchers to target disease at its most basic, causal level: the flawed instructions in the code.
The discovery of DNA’s structure gave medicine its deepest sense of purpose: to not just treat symptoms, but to correct the errors in the very instruction manual for the human body. The elegance of the double helix remains an intellectual high point in science, a visual representation of biological perfection that continues to drive the most futuristic and hopeful research in the Top 10 Most view of the future of health.
Key Highlights:
- Structure: Double helix model published in 1953, showing how genetic information is coded.
- Foundational Science: Underpins all genetics, molecular biology, and biotechnology.
- Key Enabler: Made technologies like gene sequencing, gene therapy, and CRISPR possible.
- Long-Term Impact: Allows for the correction of hereditary and acquired genetic diseases.
Top 5. Insulin Therapy
The discovery of Insulin in 1921 by Frederick Banting and Charles Best, under the guidance of John Macleod and with the critical purification work of James Collip, was a monumental triumph that immediately and dramatically saved countless lives. Type 1 diabetes, a condition where the body cannot produce the insulin hormone needed to regulate blood sugar, was an almost certain death sentence, often within months of diagnosis, particularly for children. The first clinical injection of purified insulin was described by physicians as a near-miraculous resurrection.

This discovery ranks so highly because it represented the first successful use of a hormonal replacement therapy to save the lives of people with a chronic metabolic disease. It demonstrated that complex, systemic conditions could be managed effectively by replacing a missing biological component. The ability to manage, rather than simply await the fatal outcome of, a chronic condition was a profound shift in medical possibility, allowing millions of people to live full, productive lives.
The impact of this single molecule cannot be overstated; it literally changed the prognosis for millions of individuals and transformed a swift, tragic disease into a manageable condition. Though the treatment has evolved with better delivery systems and synthetic versions, the core life-saving principle of Banting and Best’s work remains the standard of care as of November 2025.
Key Highlights:
- Discovery Date: 1921 by Banting and Best (first used on patient Leonard Thompson in 1922).
- Immediate Impact: Converted Type 1 Diabetes from a fatal illness into a manageable chronic condition.
- Medical Precedent: The first major victory using hormonal replacement therapy.
- Global Reach: Provided a life-saving treatment for millions worldwide.
Top 4. Surgical Anesthesia
Before 1846, surgery was an agonizing ordeal—a desperate, brutal race against time and the patient’s capacity for pain. The successful public demonstration of Surgical Anesthesia on October 16, 1846, by William Morton and John Collins Warren, using ether, instantly transformed surgery from a spectacle of endurance into a methodical, healing science. The ability to render a patient unconscious and insensitive to pain allowed surgeons to move beyond rapid amputations to more complex, life-saving, internal procedures.

Anesthesia is ranked fourth because it is the fundamental enabler of modern curative surgery. Without it, all the advancements in organ transplantation, heart bypass, tumor removal, and complex trauma repair would be moot. It did not cure a single disease, but it unlocked the potential of every surgeon to meticulously and safely treat deep internal pathology, saving countless lives by preventing shock, pain, and patient movement.
The removal of pain from the operating room represents a monumental humanitarian achievement, turning the surgeon’s knife into a true instrument of healing. The development of safer, more precise anesthetics continues in 2025, but the debt owed to those first demonstrations of inducing temporary, reversible unconsciousness is immeasurable.
Key Highlights:
- Inaugural Date: October 16, 1846 (First public demonstration of ether at Massachusetts General Hospital).
- Primary Role: Enabled complex, internal, and precise surgery by eliminating patient pain and movement.
- Curative Impact: Foundation for all modern surgical disciplines (e.g., neurosurgery, cardiology).
- Humanitarian Gain: Ended the agonizing suffering associated with pre-anesthesia surgery.
Top 3. Antibiotics (Penicillin)
The accidental 1928 discovery of Penicillin by Alexander Fleming, and its subsequent mass production by Howard Florey and Ernst Chain, heralded the age of effective treatments for bacterial infections. Before this, simple scratches or routine infections like pneumonia or strep throat were potentially fatal. Penicillin, the world’s first true antibiotic, provided a simple, injectable cure, transforming a world where infection was the leading cause of death into one where it was manageable.
Antibiotics occupy the third spot due to the sheer magnitude of lives saved and the profound shift they caused in the human-microbe balance. The introduction of penicillin during World War II dramatically reduced battlefield fatalities from infected wounds, and its civilian use after the war changed the calculus of daily life, making hospitalization for infection a treatment, not a final hope. The Top 10 Most recognizes that despite the current global challenge of antibiotic resistance in November 2025, the initial impact of these drugs remains one of humanity’s greatest victories.
This discovery embodies the serendipity of science, a simple mould growing on a forgotten petri dish leading to a revolution. It gave humankind a powerful chemical weapon against infectious disease, forever altering mortality rates and cementing the role of pharmacology in health care.
Key Highlights:
- Discovery: 1928 by Alexander Fleming; commercialized by Florey and Chain (1940s).
- Impact: Saved hundreds of millions of lives by treating bacterial infections like pneumonia.
- Medical Shift: Launched the entire field of antimicrobial chemotherapy.
- Current Challenge: The ongoing fight against bacterial resistance necessitates continuous new drug development in 2025.
Top 2. Vaccination (Smallpox)
The pioneering work of Edward Jenner in 1796, observing that inoculation with the milder cowpox protected against the deadly smallpox virus, established the fundamental concept of Vaccination. This single insight introduced the idea of stimulating a preventive immune response rather than waiting to treat a disease. The smallpox vaccine was refined over two centuries, ultimately leading to the complete global eradication of the disease in 1980—the only human disease ever fully conquered by medicine.

This achievement is the undisputed number two because it is the gold standard of preventative medicine, demonstrating that a deadly, widespread pathogen could be entirely removed from the planet. The principles established by Jenner’s original work underpin every single vaccine administered today, from Polio and Measles to the modern mRNA COVID-19 vaccines discussed at #10. The impact is not just in lives saved but in the permanent removal of a threat that plagued humanity for millennia.
The eradication of smallpox is a powerful symbol of international cooperation and scientific persistence. It stands as a profound testament to the power of a simple, effective, and globally distributed health intervention—an act of preventive genius that permanently secured the health of every human born since 1980.
Key Highlights:
- First Vaccine: 1796 observation by Edward Jenner using cowpox against smallpox.
- Ultimate Victory: Led to the global eradication of smallpox in 1980.
- Core Principle: Established the entire field of immunization and preventive immunology.
- Scale: Saved more lives than any other single medical treatment.
Top 1. Germ Theory
The articulation and validation of the Germ Theory of Disease by Louis Pasteur, Robert Koch, and Joseph Lister in the mid to late 19th century is the most important medical discovery of all time. This theory definitively established that many diseases are caused by microscopic, invisible organisms (pathogens). Before this, diseases were attributed to ‘bad air’ or divine retribution; afterward, the enemy was identified as the microbe, ushering in the modern era of microbiology, hygiene, and infectious disease control.

Germ Theory occupies the pinnacle spot because it provided the intellectual framework for almost every subsequent entry on this list. It explained why sanitation works (#8), why Lister’s antiseptic surgery was necessary, why vaccines are effective (#2), and why antibiotics cure disease (#3). It shifted medicine from a philosophical practice based on humors to a rigorous, laboratory-based science. All of modern infectious disease control and hygiene is a direct consequence of this discovery.
The profound simplicity of realizing that something unseen could cause such immense suffering was the ultimate wake-up call for medicine. By identifying the true cause of infectious disease, pioneers like Pasteur gave humanity the conceptual tools to fight back, transforming public health and medical practice forever. This is the truth upon which the entire edifice of Top 10 Most’s understanding of modern health stands as of November 2025.
Key Highlights:
- Pivotal Insight: Disease is caused by specific, identifiable microorganisms (germs).
- Foundation of Modern Medicine: Provided the scientific basis for sanitation, vaccination, and antibiotics.
- Impact on Surgery: Led directly to antiseptic and aseptic surgical techniques.
- Pioneer: Louis Pasteur is credited with conclusive experiments proving the theory in the 1860s.
Conclusion
The journey from John Snow’s mapping of a cholera outbreak to the current sophistication of mRNA therapeutics and CRISPR gene editing is a story of continuous, transformative human effort. The discoveries on this Top 10 Most list, particularly Germ Theory, Vaccination, and Antibiotics, didn’t just add incremental improvements; they redefined the fundamental limits of the human lifespan. They are the bedrock of global health that allows us in November 2025 to focus on complex challenges like cancer, genetic disease, and aging.
These breakthroughs prove that reasoned analytical perspective, backed by verifiable data and relentless inquiry, is the most powerful tool humanity possesses. As we look to the future, we must continue to respect and protect the great health infrastructure these discoveries have afforded us, ensuring that the legacy of these medical pioneers endure for generations to come. The next great discovery may be in personalized genomics or AI-driven diagnostics, but its success will always rest on the shoulders of the giants who first taught us how to fight the unseen.